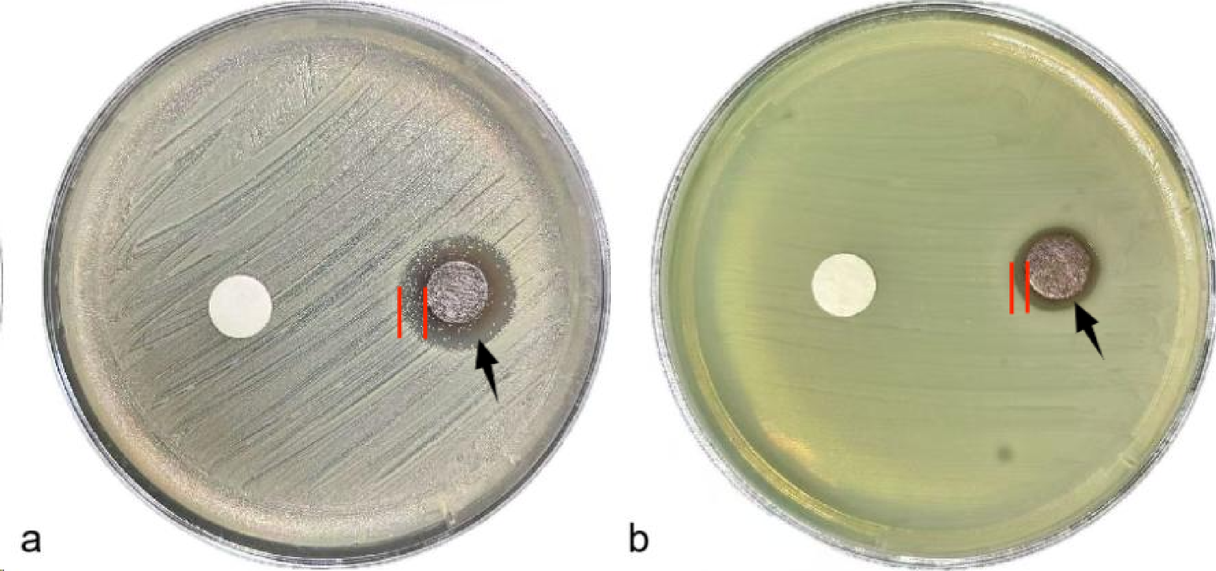
Fig. 2

Fig. 2
In Vitro Agar Plate Diffusion Experiment Diagram (a) On the right, a clear halo of inhibition is visible around the disc soaked in AgNPs/CNTs solution on the Staphylococcus aureus-inoculated plate, indicating effective antibacterial activity. In contrast, the control disc on the left, immersed in physiological saline, shows no such halo, with normal bacterial growth surrounding it; (b) Similarly, on the right side of the Pseudomonas aeruginosa-inoculated plate, the AgNPs/CNTs disc exhibits a distinct transparent zone of inhibition, while the control disc on the left is surrounded solely by green bacterial colonies, with no evidence of inhibition.
